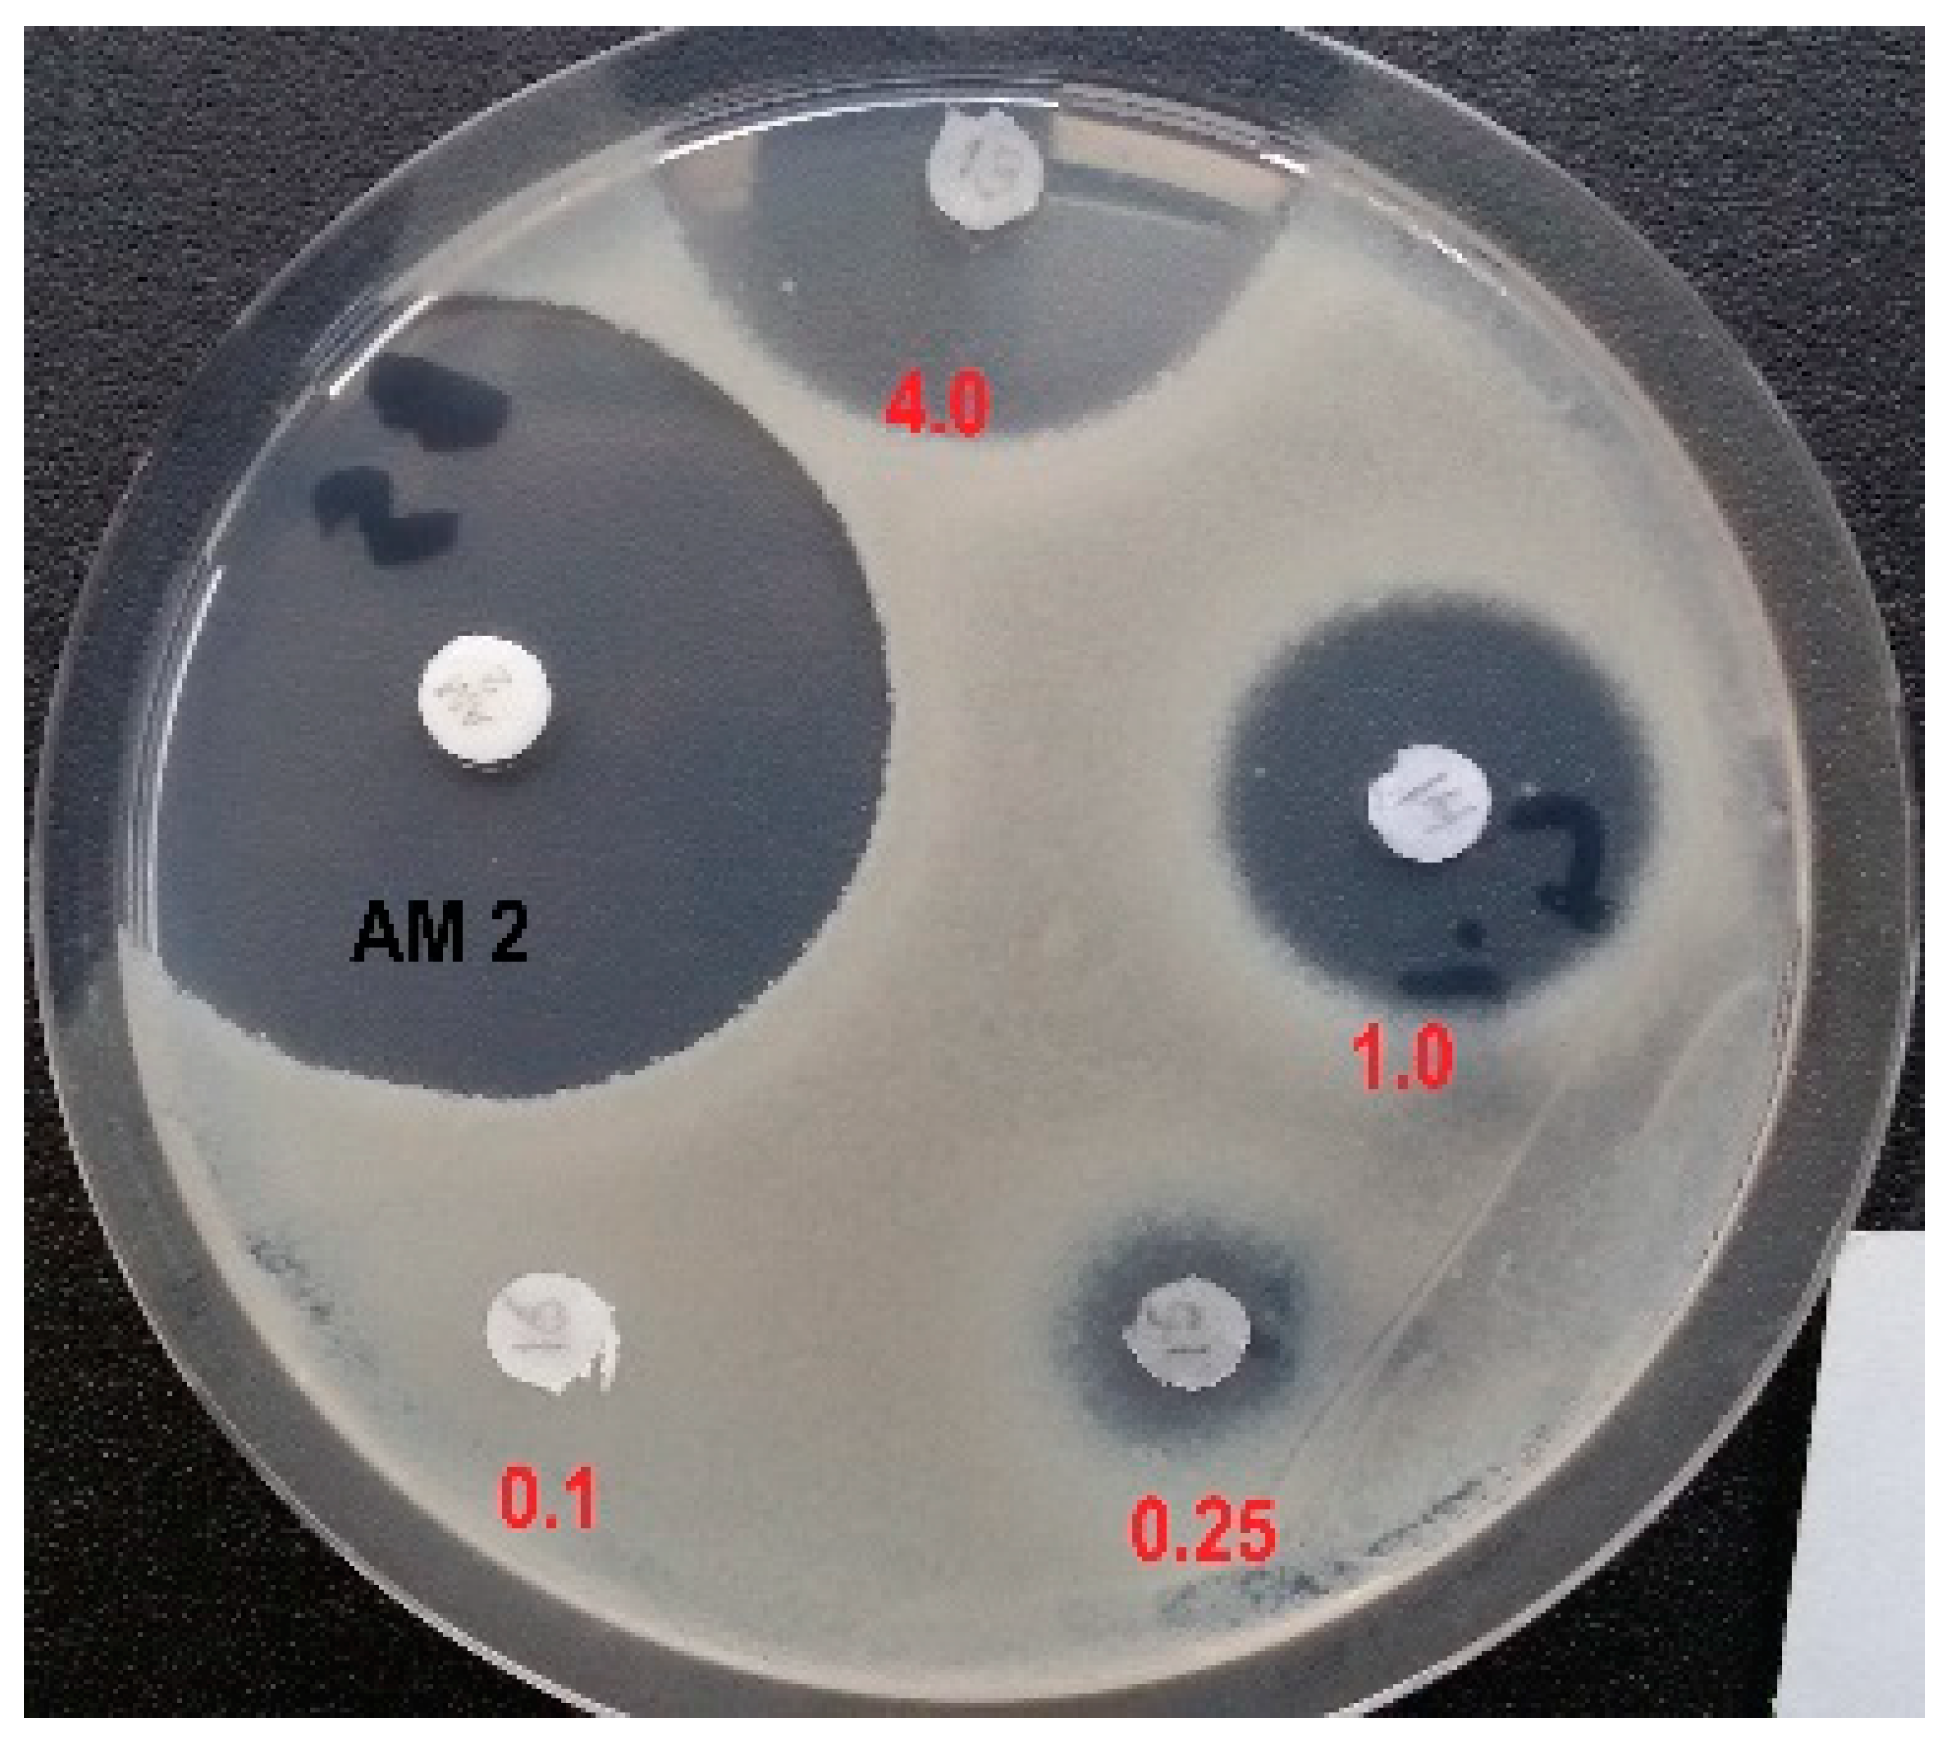
Biomolecules 13 01451 g003

1. Introduction
Organic molecules containing phosphonic and phosphinic acidic groups are unusual, though naturally occurring compounds [
1,
2,
3,
4,
5,
6]. They are characterized by the presence of a carbon–phosphorous (C-P) bond, which is rather rare in nature. In particular, phosphonates contain a single C–P bond, whereas phosphinates contain either two such bonds (i.e., C-P-C) or C-P-H bonds. For both types of compounds, the rest of the valences on the phosphorous atom are engaged in bonding oxygen. The C-P bond, unlike the C-O-P bonds, such as those occurring in the more common organic phosphate esters and anhydrides, has unique features, including a remarkable stability against enzymatic (i.e., it cannot be cleaved by hydrolyses) or chemical cleavage, such as acid/base hydrolysis. Notably, the phosphinic and phosphonic moieties structurally mimic phosphate esters, carboxylates and tetrahedral intermediates occurring during carboxyl group transformations [
3,
4]. This also explains why many of these compounds act as substrates or competitive inhibitors of the targeted enzymes. Important examples of these classes of molecules include compounds of natural origin, such as the antibiotics fosfomycin [
6], dehydrophos and plumbemycin, the antimalarial compounds fosmidomycin and FR-900098, the antifungals rhizocticins, and the herbicide phosphinothricin (PT; also known as glufosinate) [
3,
4], as well as the chemically synthesized antivirals Adefovir and Tenofovir, which are successfully employed to treat hepatitis B infections [
7]. Examples of such molecules are shown in
Figure 1a.
Given that some of the natural compounds mentioned above may also be toxic to the producing micro-organism, most of the above listed molecules are naturally synthetized as di- or tri-peptide precursors, which can enter the target cell through dipeptide or oligopeptide permeases, namely, Dpp and Opp, respectively [
3,
4,
8,
9]. Once internalized, they are cleaved by cytosolic peptidases that cause the release of the active C-P-containing amino acid. This mechanism has been referred as a “Trojan horse” or pro-drug strategy [
3,
4,
8,
9]. A remarkable example is phosphinothricin (PT; glufosinate;
Figure 1a), a non-proteinogenic amino acid, which was initially isolated as a bioactive component of the tripeptide Bialaphos, phosphinothricyl-
L-alanyl-
L-alanine. PT is a phosphinic analogue of
L-glutamate, with a phosphinic moiety (C-PO
2HCH
3) replacing the glutamate γ-carboxyl group. By mimicking the γ-phosphorylated intermediate of glutamate formed during the first step of the reaction, the pyrophosphonate of PT formed during the reaction was demonstrated to act as a competitive inhibitor of the enzyme glutamine synthetase (GS), which catalyzes the ATP-dependent formation of glutamine starting from glutamate and ammonia, [
10,
11]. In plants, the inhibition of GS leads to a rapid accumulation of intracellular ammonium ion (NH
4+), which perturbs pH homeostasis and leads to cell death. Hence, PT and the PT-containing tripeptides, Bialaphos or Phosalacine (i.e., PT-
L-alanyl-
L-leucine-), exhibit strong herbicidal activity [
3,
5,
12,
13]. In addition to the well-established herbicidal effect, Bialaphos and a PT-containing dipeptide,
L-Leu-
L-PT, were remarkably effective in clinical isolates of
Klebsiella pneumoniae, which displayed resistance to more than 20 commercial antibiotics belonging to different classes [
14].
Less investigated than PT and Bialaphos is the PT desmethylated on the phosphinic moiety (
L-2-amino-4-(hydroxy)-phosphinylbutyric acid; hereafter referred to as
L-Glu-γ-P
H;
Figure 1b), which is also an analogue of
L-glutamate, that carries the more rarely occurring
H-phosphinic group, i.e., C-P(O)(OH)H.
L-Glu-γ-P
H was originally isolated as an intermediate in the biosynthesis of Bialaphos in
Streptomyces hygroscopicus [
15] and more recently in the free form in
Nonomureae sp. NRRL B-24552 [
1]. In
S. hygroscopicus,
L-Glu-γ-P
H was shown to accumulate and inhibit growth in the mutant form of this micro-organism where the Bialaphos biosynthetic pathway was blocked [
16]. Indeed, to protect themselves from the action of the antibiotics they synthetize, the micro-organisms producing it (i.e.,
Streptomyces) initially inactivate PT, or desmethylphosphinothricin, by acetylation [
17], then the acetylated precursors are used for the synthesis of the tripeptide Bialaphos, which is released into the extracellular environment. Acute toxicity studies conducted with Glu-γ-P
H demonstrated very low toxicity of the compound. The LD
50 were 2740 mg/kg following oral administration and 1180 mg/kg following intraperitoneal injection in mice and were more than 5000 mg/kg following oral administration in rats [
18]. Notably, seven days post-administration, no histological changes were observed in the surviving animals [
18].
To date, the mechanism of antibacterial activity of
L-Glu-γ-P
H remains unknown; however, we demonstrated that the
H-phosphinic group of
L-Glu-γ-P
H is a bioisostere of carboxylates, and that the desmethylated phosphinic compounds derived from it (i.e., the
H-phosphinic analogues of GABA and succinate) can be recognized and metabolized just as the substrate by the relevant enzymes [
19]. We also found that only the
L-isomer of Glu-γ-P
H displays an antibacterial activity, which implies that the compound is indeed metabolized and leads to the formation of intermediate(s) eventually responsible for the observed antibacterial activity [
19]. To the best of our knowledge, peptides containing amino acids with a
H-phosphinic group in a distal position from the carboxyl group have never been investigated as antibacterials. Here, we studied the inhibition of growth caused by the dipeptide
L-Leu-
D,L-Glu-γ-P
H on both
Escherichia coli and
Bacillus subtilis, as representatives of Gram-negative and Gram-positive bacteria, respectively. We compared its activity with that of
D,L-PT and
L-Leu-
D,L-PT, its dipeptide derivative, as well as with the corresponding phosphonic analogues of glutamate (i.e., Glu-γ-P
5 and
L-Leu-
D,L-Glu-γ-P
5;
Figure 1b). Our data suggest that the incorporation of Glu-γ-P
H in a dipeptide significantly improves the penetration of the molecule, thus enhancing its antibacterial activity and potential use for treating bacterial infections caused by different microorganisms. This work represents additional evidence that phosphinic compounds can be regarded as interesting molecules with antibacterial activity, as recently proposed for the PT-derived dipeptide on multidrug resistant clinical isolates of
K. pneumoniae [
14].
2. Materials and Methods
2.1. Materials
D,L-Glu-γ-P
H was synthesized as described in [
20];
N-(benzyloxycarbonyl)-
L-leucine
N-hydroxysuccinimide ester (Z-
L-Leu-OSu) was prepared according to [
21] and was recrystallized from
i-PrOH before use.
L-2-Amino-4-phosphonobutyric acid (L-AP4) was obtained from Santa Cruz Biotechnology and was recrystallized from H
2O-EtOH before use; the Amoxicillin (2.0 μg per disk), was from Becton, Dickinson & Co. (Franklin Lakes, NJ, USA).
Synthesis of
L-Leucyl-
PT is described in detail elsewhere [
14].
Agar agar powder No. 1 for the bacteriology was from LobaChemie (Tarapur, India). All other reagents, salts and solvents were of the highest purity and used as supplied by Sigma-Aldrich (Burlington, MA, USA) and Acros (Cedar Rapids, IA, USA).
TLC was carried out on plastic sheet Cellulose F254 (Merck, Darmstadt, Germany) in i-PrOH–25% NH4OH–H2O = 7:1:2. L-Leu-D,L-Glu-γ-PH and L-Leu-D,L-Glu-γ-P5 were detected on TLC plates following staining with ninhydrin (0.4% in acetone).
Ion-exchange chromatography was carried out on Dowex 50W-X8, H+-form, 100–200 mesh (BioRad, Hercules, CA, USA) using water for the elution.
NMR spectra were recorded on a Bruker AM-300 (300.13 MHz for 1H, 75.43 MHz for 13C, and 121.44 MHz for 31P) using D2O as a solvent with sodium 3-trimethyl-1-propanesulfonate (DSS) as the internal, or 85% H3PO4 as the external standards. Chemical shifts are given in parts per million (ppm), while the letter “J” indicates spin–spin coupling constants which are given in Hertz (Hz).
2.2. Synthesis of L-Leucyl-D,L-Glu-γ-PH
A solution of N-Cbz-L-Leu-OSu (1.08 g, 3.0 mmol) in 1,2-dimethoxyethane (5 mL) was added to a solution containing D,L-Glu-γ-PH (500 mg, 3.0 mmol), NaHCO3 (127 mg, 1.5 mmol), Na2CO3 (158 mg, 1.5 mmol) in 1.0 M NaOH (6 mL), water (1 mL) and 1,2-dimethoxyethane (1 mL), and the reaction mixture was stirred overnight at 20 °C. The reaction mixture was concentrated in vacuo, the residue was then dissolved in water (15 mL), acidified with 37% HCl to pH = 1.0, and the separated oil was extracted with EtOAc (3 × 7 mL). The combined EtOAc extracts were washed with water (3.0 mL), brine (2 × 5 mL) and then dried (MgSO4). The solvent was removed in vacuo and the residue was dried in vacuo at 1.0 Torr at 40 °C for 1 h. The obtained foam was dissolved in glacial AcOH (3 mL), then anisole (0.2 mL) and 35% HBr/AcOH (2.2 mL) were added. The reaction mixture was incubated at 20 °C for 1.5 h (until the end of the evolution of CO2), pooled into abs. Et2O (60 mL) and left overnight at −20 °C. The solvents were decantated, the residual oil was co-evaporated in vacuo with water (2 × 10 mL), the residue was dissolved in water (10 mL) and then applied on a Dowex 50W-X8 column (V = 12 mL). A column elution was performed with water (600 mL), collecting 10 mL fractions, and then ninhydrin-positive fractions (from 15 to 50) were combined, evaporated to dryness in vacuo, and the residue was then dried in vacuo over P2O5 to give L-Leu-D,L-Glu-γ-PH (640 mg, yield 76% for two steps) as a colorless solid, with an Rf 0.66 on TLC. 1H NMR (300.13 MHz, D2O): δ = 7.02 (dm, 1H, 1JHP 514.1 Hz, H-P), 4.57–4.47 (m, 1H, CH-COOH), 4.17–4.09 (m, 1H, CH-NH2), 2.24–2.12 (m, 1H, CHa-P), 2.09–1.95 (m, 1H, CHb-P), 1.90–1.62 (m, 5H, CH2-CH2-P, CH2-CH-NH2, CH-(CH3)2), and 1.10–1.00 (m, 6H, CH-(CH3)2). 13C NMR (75.43 MHz, D2O): δ = 177.81 and 177.31 (2 × s, COOH), 173.31 and 173.20 (2 × s, CONH), 56.52 and 56.26 (2 × d, 3JPC 16.5 Hz and 3JPC 16.4 Hz, CH-COOH), 54.79 and 54.61 (2 × s, CH-NH2), 42.59 (s, CH2-CH-NH2), 30.25 and 30.05 (2 × d, 1JPC 89.3 Hz, 1JPC 89.4 Hz, CH2-P), 26.71 and 26.50 (2 × s, CH2-CH2-P), 25.82 and 25.79 (2 × s, CH-(CH3)2), 24.39 and 24.35 and 23.94 and 23.91 (4 × s, CH3).31P NMR (121.44 MHz, D2O): δ = 29.34 and 29.17 (2 × s). The symbol “×” indicates differences of the same signals and coupling constants of L,L- and L,D-diastereomers. HRMS (ESI-MS): found m/z 281.1261; calc. for C10H21N2O5P [M+H]+ 281.1266.
2.3. Synthesis of L-Leucyl-D,L-Glu-γ-P5
This dipeptide was prepared as described for
L-
Leu
-D,
L-Glu-γ-P
H (see
Section 2.2) starting from
D,
L-AP4 (366 mg, 2.0 mmol) and
N-Cbz-
L-Leu-OSu (716 mg, 2.0 mmol) in a H
2O-1,2-dimethoxyethane mixture. After the deprotection of the crude N-Cbz-dipeptide with 35% HBr/AcOH and the removal of the access of HBr/AcOH as described in
Section 2.2, the residue was dissolved in H
2O (10 mL) and applied on a Dowex 50WX8 column (V = 12 mL). The column was eluted with water (700 mL), collecting 10 mL fractions, and then ninhydrin-positive fractions (from 25 to 60) were combined, evaporated to dryness in vacuo and the residue was then dried in vacuo over P
2O
5 to afford
L-Leucyl-
D,
L-Glu-γ-P
5 (320 mg, with a yield of 54% for two steps): R
f 0.29.
1H NMR (300.13 MHz, D
2O): δ = 4.44–4.32 (m, 1H, C
H-COOH), 4.00 (dd, 1H,
3J
HHa 7.5 & 7.4 Hz,
3J
HHb 7.4 & 6.7 Hz, C
H-NH
2), 2.15–2.01 (m, 1H, CH
a-P), 2.00–1.85 (m, 1H, CH
b-P), 1.77–1.54 (m, 5H, C
H2-CH
2-P, C
H2-CH-NH
2, C
H-(CH
3)
2), and 0.98–0.85 (m, 6H, CH-(C
H3)
2).
13C NMR (75.43 MHz, D
2O): δ = 178.12 and 177.55 (2 × s, COOH), 173.30 and 173.19 (2 × s, CONH), 56.84 and 56.50 (2 × d,
3J
PC 17.5 Hz and
3J
PC 17.3 Hz,
CH-COOH), 54.81 and 54.62 (2 × s, CH-NH
2), 42.58 (s,
CH
2-CH-NH
2), 27.90 and 27.88 (2 × s,
CH-(CH
3)
2), 26.94 and 26.68 (2 × d,
1J
PC 134.5 Hz and
1J
PC 134.7 Hz, CH
2-P), 26.70 and 26.50 (2 × s,
CH
2-CH
2-P), 24.39 and 24.35 and 23.93 and 23.91 (4 × s, CH
3).
31P NMR (121.44 MHz, D
2O): δ = 24.93. HRMS (ESI-MS): found
m/
z 297.1210; calc. for C
10H
21N
2O
6P [M+H]
+ 297.1215.
2.4. The Microdilution Method to Determine the Antimicrobial Activity of Tested Compounds against Escherichia coli
The minimum inhibitory concentration able to inhibit 90% (MIC
90) of the the growth of the bacterial population of the test strain
E. coli K12 MG1655 was calculated using the broth microdilution method in the minimal medium EG containing MgSO
4•7H
2O (0.2 g), citric acid•H
2O (2.0 g), anhydrous K
2HPO
4 (10.0 g), NaNH
4HPO
4•H
2O (3.5 g), and glucose (4.0 g), milliQ water (1.0 L), at a final pH of 7.0 as described elsewhere [
19]. Briefly, overnight cultures (2 mL) of the
E. coli K12 strain MG1655 grown in LB (lysigeny broth) medium were centrifuged at 3500 rpm for 15 min at 15 °C and the bacterial cellular pellets resuspended in an isovolume of saline solution (9 g/L NaCl). The OD
600 was then brought to 1.0. The resuspension of the bacterial cells was used to inoculate (1:25) 2 mL of fresh minimal medium EG and the bacteria were allowed to grow for 6 to 7 h at 37 °C from a starting OD
600 = 0.04 to a final OD
600 = 0.5 (corresponding to 2.5 × 10
8 colony forming units, cfu/mL), then diluted (1:25) to a final OD
600 = 0.02 (corresponding to 1.0 × 10
7 cfu/mL) in the same minimal medium. This dilution was the one used to set up the 96-well microplate containing a geometrically increasing concentration of the compounds to be tested. In the microplate, 20 µL of bacterial culture (OD
600 = 0.02) were added to a final volume of 200 µL. Thus, a 1:10 dilution was made and the starting OD
600 in the microplate reader was 0.002, corresponding to a number of cfu/mL at time zero, as assessed by plating on LB-agar, between 0.5–1.0 × 10
6/mL. This corresponds to the optimum starting number of cfu/mL to perform an MIC experiment. The microplate was incubated at 37 °C for 24 h in the microplate reader Varioskan Lux (ThermoFisher Scientific, Monza, Italy). The OD
600 was recorded automatically every hour. Before each reading, the microplate was set to shake vigorously for 10 s, to ensure an even distribution of the bacteria in solution. The MIC
90 was calculated at 22 h from the inoculum using the equation: % inhibition = [1 − (OD
600treated/OD
600untreated)] × 100.
Unless otherwise specified, all the tested compounds were dissolved in Milli-Q water, pH-adjusted to 7–8 by adding 5.0 N NaOH, filtered, dispensed in aliquots and stored at −20 °C.
2.5. The Agar Diffusion Method to Analyze Antimicrobial Activity of L-Leucyl-D,L-Glu-γ-PH against Bacillus subtilis ATCC 6633
Different amounts of
L-Leu-
D,
L-Glu-γ-P
H were applied to paper disks. The disks were dried in air and placed on the surface of an agar medium for
B. subtilis [
22], containing Gibco (New York, NY, USA) potato starch (25.0 g), glycerol (2.5 g),
L-Asp (2.0 g),
D,
L-Met (0.4 g), K
2HPO
4 (6.0 g), KH
2PO
4 (2.0 g), NH
4Cl (1.0 g), NH
4NO
3 (0.2 g), Na
2SO
4 (0.2 g), MgSO
4•7H
2O (0.04 g), MnSO
4•4H
2O (0.002 g), FeSO
4•7H
2O (0.002 g), CaCl
2 (0.001 g), agar (15 g), and milliQ water (1.0 L), with a final pH of 6.8, with a seeded lawn of
B. subtilis ATCC 6633 strain with a seeding density of 10
6 bacteria per 1 cm
2 of agar surface. The dishes were incubated for 20 h at 37 °C. Amoxicillin (2.0 μg per disk) was used as a control. The antibiotic activity was determined by the agar diffusion method based on the presence and size of non-growth zones around the disks [
23].
4. Discussion
The substitution of the carboxyl group of amino acids with a phosphorus-containing group leads to two main families of analogues, namely, the phosphinic and the phosphonic organophosphorous compounds. The latter -P(O)(OH)
2 group has a tetrahedral spatial organization, with a double negative charge at a neutral pH, and is unable to mimic the planar single-charged carboxyl group of the amino acids, as we already demonstrated by modelling studies [
19]. In agreement, aminophosphonic acids are reported to be poor inhibitors of the enzymes of amino acid metabolism [
29]; however, among the derivatives of aminophosphonic acids, i.e., esters, amides and the compounds with a C-P-C backbone, which are stable mimics of tetrahedral intermediates (or reaction transition states) of carboxyl group transformations, there are not only potent enzyme inhibitors, but even commercial drugs [
9,
29]. Notable examples are the compounds listed in the Introduction (with some depicted in
Figure 1a) including PT, which inhibits GS [
10,
11]. Another notable example is a peptidomimetic containing a phosphonate moiety in place of the peptide bond, namely, Fosinopril
®, which acts as an inhibitor of the zinc-dependent angiotensin-converting enzyme and is used to treat hypertension [
30].
By contrast, the substitution of one hydroxyl group of aminophosphonic acids with a hydrogen atom eliminates one negative charge as well a bulky atom (i.e., oxygen) and confers to the
H-phosphinic group a flattened tetrahedral geometry as suggested by crystallographic data for the β-
H-phosphinic analogue of aspartate [
31]. The
H-phosphinic group can indeed be considered as a bioisostere of the carboxyl group, as confirmed by several substrate-like transformations of α-amino-
H-phosphinic acids ([
19] and ref. therein).
The demethylphosphinothricin, Glu-γ-P
H (
Figure 1b), was first discovered and isolated from
Streptomyces hygroscopicus and
S. viridochromogenes [
15] as a key intermediate of the biosynthetic pathway leading to Bialaphos (a tripeptide containing phosphinothricin, i.e., PT, and two alanyl residues), a well-known commercial herbicide [
32]. The key biochemical feature of Glu-γ-P
H is the presence of two pharmacophores in the molecule, i.e., the
H-phosphinic group replacing the γ-carboxyl group and the α-amino acid moiety (
Figure 4). This explains the ability of Glu-γ-P
H to undergo some substrate-like transformations via α-amino acid moiety leading to metabolites containing unusual C-P-H bonds (see the blue pathways in
Figure 4), as recently demonstrated [
19]. Some of the de novo synthesized metabolites may be those responsible for the observed antibacterial activity.
It is known that
L-Glu-γ-P
H is a substrate of the PLP-dependent enzyme aspartate aminotransferase, giving rise to a
H-phosphinic analogue of α-ketoglutarate, i.e., 2-oxo-4-phosphinobutyric acid (hereafter referred to as α-KG-γ-P
H;
Figure 4, reaction 1) [
33].
L-Glu-γ-P
H is a substrate of
E. coli GABA transaminase producing α-KG-γ-P
H [
34]. According to our preliminary observations (unpublished), α-KG-γ-P
H is also formed in the NAD-dependent glutamate dehydrogenase reaction (
Figure 4, reaction 2). As a consequence of one of the above reactions, α-KG-γ-P
H may enter the TCA cycle and cause antibacterial activity by acting as an inhibitor of central metabolism.
L-Glu-γ-P
H was also found to be the substrate of the PLP-dependent enzyme glutamate decarboxylase from
E. coli, yielding the
H-phosphinic analogue of GABA, GABA-P
H (
Figure 4, reaction 3), which then undergoes transamination by GABA-transaminase, and the resulting 3-phosphinopropionic aldehyde (the
H-phosphinic analogue of succinic semi-aldehyde) is then oxidized in a NAD-dependent reaction to the
H-phosphinic analogue of succinate by succinic semialdehyde dehydrogenase [
19]. Since the
H-phosphinic group is a bioisostere of the carboxyl group, it cannot be excluded that
L-Glu-γ-P
H may be a substrate of glutamyl-tRNA synthetase (
Figure 4, reaction 4) with a subsequent formation of peptides carrying a few
L-Glu-γ-P
H residues (though the incorporation of
L-Glu-γ-P
H is not expected to occur to a significant extent because of the competition with the much more abundant
L-glutamate in the glutamyl-tRNA synthetase reaction). It is also plausible that
L-Glu-γ-P
H undergoes PLP-dependent racemization to generate
D-Glu-γ-P
H (
Figure 4, reaction 5) which, however, will not be involved in the biosynthesis of peptidoglycan (murein), an important component of the bacterial cell wall, due to the different chemistry of the carboxyl and
H-phosphinic groups.
When considering the antibacterial activity of
L-Glu-γ-P
H, the contribution of the second pharmacophore, the distal
H-phosphinic group, must be taken into consideration. Transformations of γ-carboxyl group of the natural amino acid
L-glutamate lead to the formation of glutamine (for nitrogen assimilation), glutathione (an essential antioxidant), and dihydrofolate (essential in reactions involving the transfer of one-carbon units). Moreover, transformations of the γ-carboxyl group of
L-glutamate are involved in the biosynthesis of proline and ornithine. All the listed reactions lead to the formation of γ-glutamyl phosphate, or γ-glutamyl adenylate, an intermediate through ATP-dependent ligation, which is a key step in the biosynthesis of the above important metabolites. The intermediate formation of such activated
L-Glu-γ-P
H derivatives is in principle possible, since the
H-phosphinic analogues of methionine and valine are substrates of the ATP-PPi exchange reaction catalyzed by Met- and Val-aminoacyl-tRNA synthetases [
35]; however, the transfer of Met- and Val
H-phosphinic analogues to the 3′-end of tRNA was not observed and is biochemically impossible because the corresponding enzymes are highly complementary only to the tetrahedral transition state of a carboxyl group, while the transition state of a
H-phosphinic group is a trigonal bipyramid. These considerations a priori restrict the substrate-like transformations of
L-Glu-γ-P
H via the
H-phosphinic group (
Figure 4, pathways 6–10). Thus, while
L-Glu-γ-P
H may be expected to inhibit the glutamine, glutathione, dihydrofolate, proline, and ornithine biosynthetic pathways, it is difficult to predict how efficient this inhibition would be.
Based on the above, the antibacterial activity of
L-Leu-
D,
L-Glu-γ-P
H, which penetrates in bacteria via the peptidyl permease system and upon cleavage via peptidases, releases the antibacterial
L-Glu-γ-P
H. This may occur either via the biochemical transformation of its α-amino acid moiety (
Figure 4), giving rise to new biologically active metabolites containing a C-P-H bond, or by interfering with the transformations at its γ-position due to the presence of a
H-phosphinic group.
In this work we observed that the phosphonic dipeptide
L-Leu-
D,
L-Glu-γ-P
5 was significantly less active against
E. coli when compared to
L-Leu-
D,
L-Glu-γ-P
H (
Table 1). It is possible that such a difference may be due to their differences in bioavailability, although phosphonopeptides are known to effectively penetrate bacteria using peptidyl permeases [
9,
26,
34]. In our opinion these differences are more likely due to the inability of Glu-γ-P
5, released in the cytosol after dipeptide cleavage, to undergo substrate-like transformations (reactions 1–5 in
Figure 4) that lead to new biologically active phosphonic compounds, which is likely to occur with
L-Glu-γ-P
H (
Figure 4). This is in line with the inability of
D,
L-Glu-γ-P
5 to act as either a substrate or an inhibitor of
E. coli glutamate decarboxylase [
19,
36] and porcine heart aspartate aminotransferase [
33]. On the other hand, the phosphonic group is a doubly-charged tetrahedral group which mimics the tetrahedral intermediates (or reaction transition states) of the carboxyl group [
9,
29] and this explains the rather high competitive inhibition (K
I 50 µM) of
E. coli glutamine synthetase (GS) with Glu-γ-P
5 [
37]. However, PT (see Introduction and
Figure 1a), a naturally occurring inhibitor of GS, can undergo ATP-dependent ligation, with the formed pyrophosphonate that mimics the phosphorylated intermediate of glutamate occurring in the GS-catalyzed reaction [
10,
11]. Notably, PT has K
I 0.6 µM against the
E. coli GS [
38]. These differences in the inhibitory activities of Glu-γ-P
5 and PT may partly explain the differences observed in the activities of
L-Leu-
D,
L-Glu-γ-P
5 and
L-Leu-
D,
L-PT against
E. coli: the first dipeptide has a MIC
90 = 80 µg/mL, while the second has a MIC
90 = 0.1 µg/mL (
Table 1).
5. Conclusions
Antibiotics are chemical substances used to treat bacterial infections in human and veterinary diseases. It is generally agreed that antibiotics’ discovery in the 20th century has revolutionized modern medicine by enabling the treatment of life-threating infectious diseases and allowing major advances in modern medicine, such as surgery and chemotherapy. In the last decades, however, the over- and mis-use of antibiotics, along with the lack of development and innovation in this field has exacerbated the phenomenon of the emergence and spreading of antibiotic resistant bacteria. To avoid a return to the pre-antibiotic era, we urgently need additional antibiotics with new pharmacophores and mechanisms of action.
Given the abundance and the many key roles played by glutamate in microbial metabolism, Glu-γ-P
H may affect one or more of the metabolic pathways in which glutamate is involved. For this multi-target potential, which would significantly delay the appearance of resistance mechanisms, Glu-γ-P
H is a new promising antibacterial. Notably, acute toxicity studies conducted with Glu-γ-P
H on rats and mice have showed very low toxicity [
18]. To the best of our knowledge, amino acid derivatives containing a γ-phosphinic group have never been tested as an antibacterial. Our findings, in addition to previously published results, strongly suggest that the antibacterial activity of
L-Glu-γ-P
H can be attributed to the formation of
H-phosphinic intermediates through substrate-like transformations involving the α-amino acid moiety. The mechanism of action of
L-Glu-γ-P
H is still unknown and its antibacterial activity cannot be directly attributed to a specific pharmacophore, i.e., the α-carbon moiety and/or the γ-phosphinic moiety (
Figure 4); however, the present work provides evidence that
H-phosphinic compounds are attractive molecules with antibacterial activity on a novel metabolic target, with an important potential in treating multidrug-resistant pathogenic microorganisms.